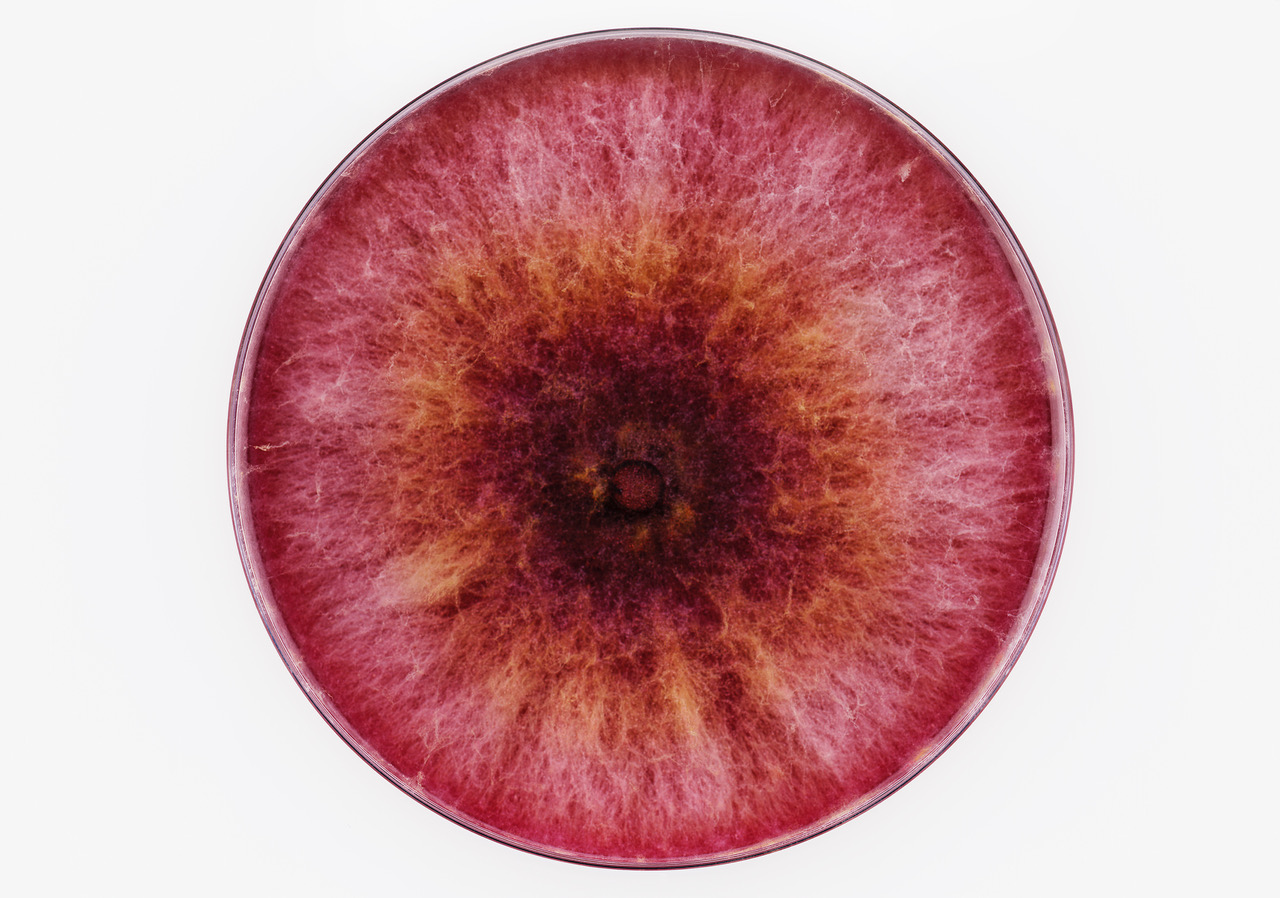

Det skal du se! uge 35
Vi anbefaler her en håndfuld kunstudstillinger, som enten lige er åbnet, eller som åbner snart. Du kan også få det fulde overblik i vores Art Guide.
Vi anbefaler her en håndfuld kunstudstillinger, som enten lige er åbnet, eller som åbner snart. Du kan også få det fulde overblik i vores Art Guide.
Vi anbefaler her en håndfuld kunstudstillinger, som enten lige er åbnet, eller som åbner snart. Du kan også få det fulde overblik i vores Art Guide.
umbrella | west coast exhibitions
2 sep – 11 nov, Nicolai Howalt: F.U.N.G.I.
F.U.N.G.I., der er skabt i samarbejde med Botanisk Museum, NovoZymes og professor i mykologi Henning Knudsen, viser en “ny samling” af svampe baseret på andre parametre end strengt videnskabelige eller botaniske. Værket, der krydser grænserne mellem videnskab og kunst, berører spørgsmål om eksistentiel økologi, tid og billeders fænomenologi samt svampenes betydning for vores liv og vores planet.
Kunstbygningen i Vrå
3 sep – 19 nov, Fremtidens rum og væren
I denne udstilling mødes billedkunstnere og arkitekter i en kunstnerisk udforskning af fremtidens bæredygtige liv og omgivelser. Kunsten tilbyder et åbent og visionært rum hvor utopier, viden og praksis kan mødes på tværs, og udføre grundlæggende tankeeksperimenter og visualiseringer af en mulig fremtid. Her er det ikke dystopierne vi dyrker, men snarere de positive bud på en nærtliggende fremtid.
KH7 artspace
1 sep – 16 sep, Lars Worm: Vækst
1 sep – 16 sep, Mikkel Høgh Kaldal: Pretend like nothing happened
Udstillingen Vækst handler om konsekvenserne af et kapitalistisk system baseret på vækst og pengenes magt, og den misvækst der følger på andre fronter. Kaldal udforsker sammenhængen mellem mønstre, billeder og fortællinger og deres forbindelse til minder, der gør det muligt for os at huske i længere perioder.

Den Frie Udstillingsbygning
1 sep – 29 okt, På Korte Kontrakter
På Korte Kontrakter er en udstillingsrække, der sætter fokus på de vilkår, kunstnere ofte arbejder under: Hvem har ret til at være i byen? Hvem er det, der styrer byens udvikling? Hvordan skabes en mere blandet by? Udover de tre udstillinger på Den Frie omfatter På Korte Kontrakter også sideløbende udstillinger i atelierfællesskaberne AGA Works, Holckenhus samt i Nikolaj Kunsthal.
SIMIAN
26 aug – 15 okt, CRY ME A RIVER
Udstillingen undersøger økonomiske forhold, identiteter, global handel, vold og samtidskunsten i sig selv. De deltagende kunstnere opfordrer besøgende til at reflektere over, og genoverveje, de indbyrdes relationer i udstillingen og deres eget forhold til objekter, til kunstige og til naturlige omgivelser.
Artspace Transit
1 sep – 20 okt, Viktor-Emil Dupont Billund: RASHOMON
Vi er omringet af kulturelle symboler og tegn. Hvordan kan vi kritisk undersøge symbolernes effekt på vores tænkning og kultur? Hvilke iboende demokratiske, politiske og miljømæssige aftryk sætter de? Med fokus på kommunikation, transport og information præsenterer Billund en sammensat række tegn og symboler med forskellige historiske udgangspunkter og perspektiver.